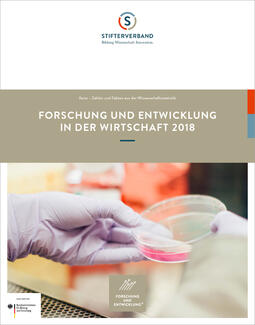
FuE-facts 2018 (Cover)

Forschung und Entwicklung in der Wirtschaft 2018
facts – Zahlen und Fakten aus der Wissenschaftsstatistik
Auf acht Seiten fassen die facts die zentralen Ergebnisse der im Auftrag des Bundesministeriums für Bildung und Forschung von der Wissenschaftsstatistik im Stifterverband durchgeführten Datenerhebung zu Forschung und Entwicklung (FuE) im Jahr 2018 zusammen.
FuE-Aufwendungen der Wirtschaft stiegen 2018 um 4,8 Prozent.
Um 3,3 Milliarden Euro sind 2018 die Ausgaben der deutschen Wirtschaft für eigene Forschung und Entwicklung (FuE) im Vergleich zum Vorjahr gestiegen. Die Unternehmen erhöhten ihre internen FuE-Aufwendungen nominal um 4,8 Prozent auf 72,1 Milliarden Euro und stockten ihr Forschungspersonal um 3,3 Prozent auf 451.000 Vollzeitäquivalente auf. Die externen FuE-Aufwendungen – also der Wert von Forschungsaufträgen, die an andere Unternehmen, Hochschulen oder staatliche Forschungseinrichtungen vergeben werden – erhöhten sich um 6,1 Prozent auf 20,7 Milliarden Euro. Das ist das Ergebnis der aktuellen FuE-Datenerhebung der Wissenschaftsstatistik des Stifterverbandes im Auftrag des Bundesministeriums für Bildung und Forschung (BMBF). Mit 3,13 Prozent erreichen Wirtschaft und öffentliche Hand erneut deutlich das Ziel der Strategie Europa 2020, drei Prozent des Bruttoinlandsprodukts (BIP) für Forschung und Entwicklung auszugeben ("FuE-Quote").
Die Publikation ist im März 2020 erschienen.
Mehr Info
Kontakt
Bernd Kreuels
ist wissenschaftlicher Referent in der FuE-Erhebung in der Wissenschaftsstatistik des Stifterverbandes.
T 0201 8401-413